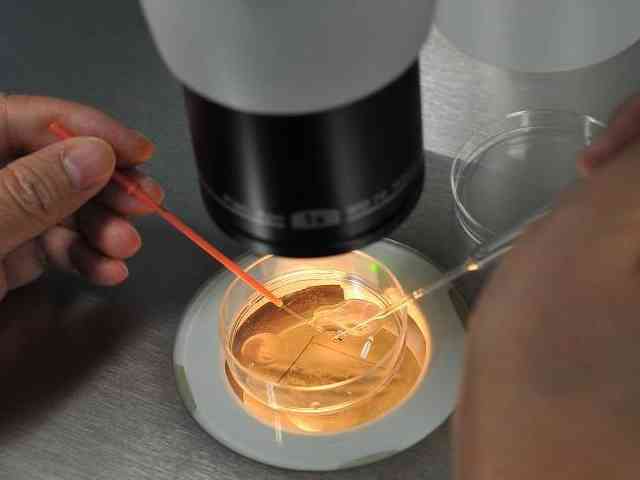

四川省婦幼
依使用者真實經歷、反饋整理四川省婦女兒童醫院生殖中心成功率資料參考,綜合疾病、方案、需求等多維度彙總四川省婦幼醫院試管嬰兒專家擅長,同步更新四川省婦幼醫院生殖醫生成功率實時排名,幫助更多人發現四川省婦幼醫院試管嬰兒專家誰最好。

四川省婦幼三代試管真能選男女,能不能做有這兩種情況
很多的父母比較偏愛男孩,包括不孕的家庭裡面,也有很多人希望自己能夠通過試管挑選胚胎性別生兒子。雖然從醫學上看,三代試管技術可以定向選擇男胚或者女胚,不過四川省婦幼保健院是一家公立的三級甲等婦幼保健院,一般不會違反規定做性別鑑定。該醫院可以做三代試管,但是隻能為那些有性別遺傳疾病的患者挑選胚胎,定向選擇男孩或者女孩。四川省婦幼保健院三代試管可不可以選擇性別:三代試管技術優勢是顯而易見的,不僅可以於染...

多情不義必自斃
07-05
四川省婦幼試管檢查專案一覽,男方雙方各不相同仔細看
四川省婦幼試管進周前夫妻需要檢查有很多很多,如女方需要做的檢查有抽血檢查、白帶檢查以及染色體檢查等,男方需要做的檢查有抽血檢查、精液檢查以及遺傳檢查等。一般來說,做這些檢查的目的就是看夫妻是否具有做試管的指徵,以及便於試管醫生根據女性患者身體情況制定相應的促排卵方案,以提高試管助孕的成功率,所以大家在做這些檢查的時候,一定要積極配合醫生,才能提高檢查結果的準確率。四川省婦幼試管進周前夫妻檢查專案無...

猴皮筋
07-05
2023四川省婦幼三代試管費用匯總,內含五大專案明細
四川省婦幼保健院做一次三代試管大約費用在50000-100000元左右。一般來說,其費用大致就包括了試管嬰兒術前雙方檢查費用,約需5000元左右;促排卵藥物費用:進口藥約250元左右一支,國產藥物一支約需120元左右,一次大概需要20到30支;取卵手術加胚胎培養費約需6000元左右;胚胎檢測費用約需3-5萬元左右;移植費用約需5000元左右。四川省婦幼三代試管費用明細三代試管即胚胎植入前遺傳學診斷...

白蘭國
07-05
四川省婦幼保健院試管成功率高,鮮胚、囊胚和凍胚差異不大
四川省婦幼保健院試管移植成功率大概多少還是與不孕不育患者所選擇的試管移植技術有一定的關係。一般來說,試管移植助孕技術大致就有三種,第一種就是鮮胚移植,該技術助孕成功率在40%-45%左右;第二種就是囊胚移植,該技術助孕成功率在45%-55%左右;第三種就是凍胚移植,該技術助孕的成功率在45%-50%左右。但是其助孕期間也會由於胚胎質量而影響其成功率各有不同。四川省婦幼保健院生殖醫學開設了不孕不育門...

佝僂貓
07-04
四川省婦幼保健院生殖科試管醫生top10,這幾位口碑上佳
四川省婦幼也就是我們常說的四川省婦幼保健院、成都醫學院附屬婦女兒童醫院,成立於1988年,現目前已經是一家三級甲等婦幼保健機構,設有生殖科、婦產科、男科、新生兒科等,其中生殖科每天的人流量是很大的,很多當地、外地的不孕不育患者都會前來診治,不過對於選擇在該院生殖科進行助孕的,最好的就是選擇一個優質的醫生,但是目前生殖科的醫生都是比較出名的,大家可以結合自己的實際情況選擇。四川省婦幼保健院生殖科試管...

段小潔
07-04
四川婦幼保健院試管費用、成功率一覽,關鍵看患者身體情況
四川省婦幼保健院成立於1988年,系四川省衛生健康委直屬非營利性事業單位和成都醫學院附屬婦女兒童醫院,是一家三級甲等婦幼保健機構,更是四川省第一家可以開展輔助生殖技術的醫院。現在醫院可以常規開展夫精人工授精技術、第一代試管嬰兒技術、第二代試管嬰兒技術、第三代試管嬰兒技術、胚胎冷凍儲存技術、囊胚培養技術、早孕減胎術等。四川省婦幼保健院生殖醫學中心四川省婦幼保健院生殖醫學中心是四川省生殖醫學重點學科,...

韓東東
07-03
不建議去四川省婦幼做試管是謠言,技術有保障經國家認證
並沒有關於不建議去四川省婦幼保健院做試管的說話,四川省婦幼做試管的技術可以說是很優秀的,在生殖領域上面可以說是具有一定地位的,很多的本地人和外地人都會慕名前來做試管,所以在試管技術方面是有保障的,是得到了國家的認準的。也是四川省醫保定點單位,設有四川省婦幼健康和計劃生育研究所、四川省產前診斷中心、四川省新生兒疾病篩查中心、四川省兒童醫學中心等機構。四川省婦幼簡介四川省婦幼保健院始建於1988年,醫...

我是你的驕傲嗎
07-02
四川省婦幼做試管技術好不好?全年達到1萬人次真不是吹
四川省婦幼做試管的技術可以說是很好的,該醫院在生殖領域上面的地位還是很不錯的,成功率基本都是在50%左右的,已經處於我國試管嬰兒技術的平均水平了,所以四川省婦幼保健院的試管技術是很好的。四川省婦幼保健院是四川境內能做試管的醫院之一,該醫院的試管技術是經過國家的檢驗才批准開展的,不管是設施裝置,還是技術都是得到了過節一致認可的,是可以放心的。四川省婦幼保健院簡介四川省婦幼保健院成立於1988年,現目...

藍臉的道爾頓
07-01








